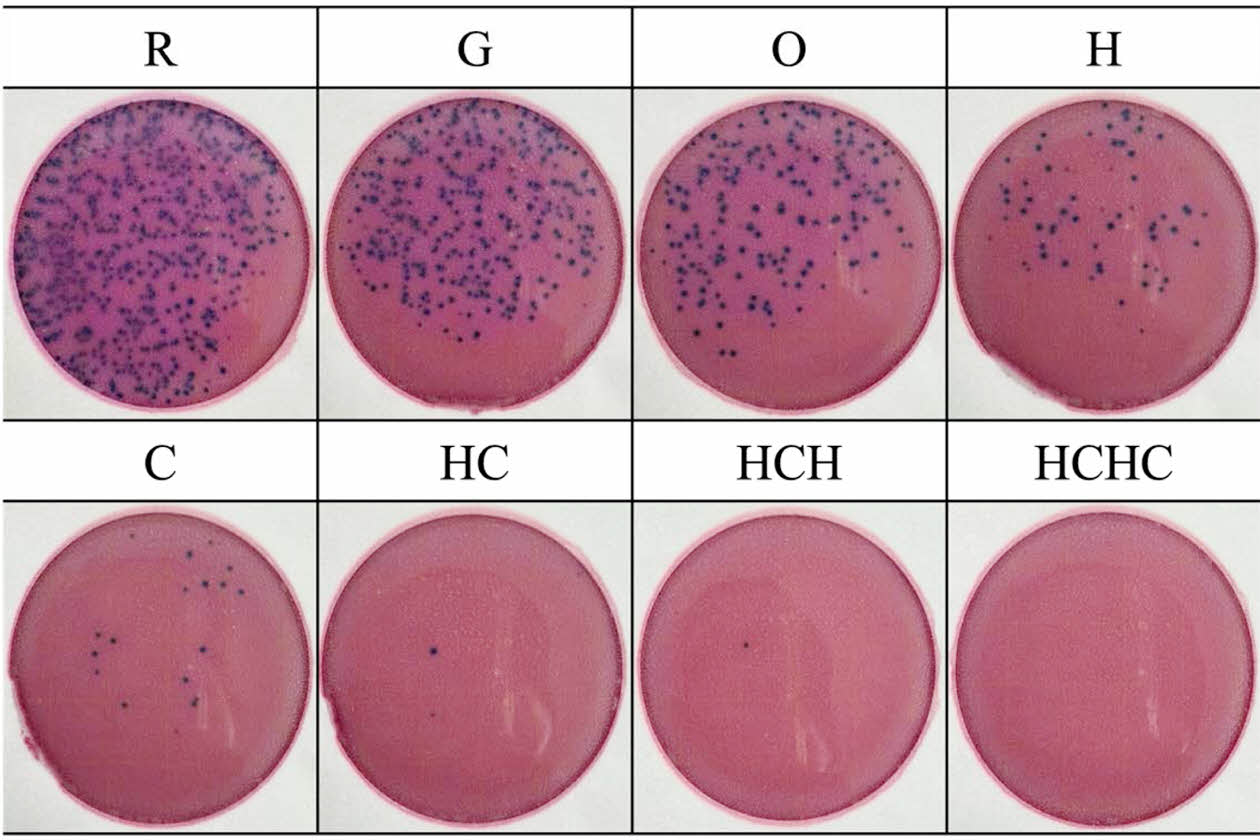

- Drug Release and Characterization of Multilayer Coated Contact Lenses with Natural Polysaccharides
Sun-Woo Sim, Ga-Hyoung Son, Yoon Jung Jang*,†
 , and Hyun Mee Lee†
, and Hyun Mee Lee† 
Department of Optometry and Vision Science, Daegu Catholic University, Gyeongbuk 38430, Korea
*Chunma College of General Studies, Yeungnam University, Gyeongbuk 38541, Korea- 천연다당류로 다층코팅된 콘택트렌즈의 약물방출 및 특성
대구가톨릭대학교 안경광학과, *영남대학교 천마학부대학 교양학부
Reproduction, stored in a retrieval system, or transmitted in any form of any part of this publication is permitted only by written permission from the Polymer Society of Korea.
This study aimed to increase the loading of the antibiotic gatifloxacin in silicone hydrogel contact lenses through oleic acid treatment and to improve sustained drug release and physical properties using layer-by-layer (LBL) multilayer coatings with hyaluronic acid and chitosan. The interaction with oleic acid increased the drug loading, and LBL coating significantly enhanced the drug release duration. Specifically, as the number of coating layers increased, the water content also increased, and the antibacterial efficacy was strengthened, providing prolonged protection against microorganisms. The formation of LBL multilayer coatings with natural polysaccharides like hyaluronic acid and chitosan extended the drug release duration and improved the physical properties.
본 연구는 실리콘 하이드로겔 콘택트렌즈에 올레산 처리를 통해 항생제 가티플록사신의 탑재량을 증가시키고, 히알루론산과 키토산을 이용한 layer-by-layer(LBL) 다층 코팅으로 지속적인 약물 방출 및 물리적 특성을 향상시키는 것을 목적으로 하였다. 올레산과의 상호작용으로 약물 탑재량이 증가했으며, LBL 코팅은 약물 방출 지속성을 크게 개선하였다. 특히, 코팅층이 증가할수록 함수율이 증가하였으며, 향균성이 강화되어 장기간 미생물에 대한 보호 효과가 지속되었다. 히알루론산과 키토산과 같은 천연 다당류로 LBL 다층 코팅을 형성함으로써 약물 방출 지속 시간이 연장되고, 물리적 특성이 향상되었다.
Contact lenses were loaded with gatifloxacin and multilayer-coated with hyaluronic acid and chitosan to evaluate drug release and physical properties. The multilayer-coated lenses showed longer sustained drug release than the single-layer-coated samples, and the drug release time was further extended as the number of coating layers increased.

Keywords: contact lens, layer-by-layer coating, oleic acid, gatifloxacin, hyaluronic acid, chitosan.
This research was supported by the National Research Foundation of Korea (NRF) grant funded by the Korea government (No. 2021R1F1 A106332211).
The authors declare that there is no conflict of interest.
With the advancement of the information society and the widespread use of smartphones, more people are using contact lenses to improve their vision and for cosmetic reasons. However, this growing trend has raised concerns about eye health. Wearing hydrogel contact lenses has been linked to ocular diseases,1,2 changes in corneal thickness,3,4 and alterations in corneal curvature and visual acuity due to hypoxia.2,5
In response, many studies have examined the physical properties,6 therapeutic lenses, antimicrobial properties,7 and colored varieties of contact lenses8 to enhance user experience. The use of silicone hydrogel lenses with high oxygen permeability is also on the rise.9,10
Due to their hydrophobic nature, silicone hydrogel contact lenses are prone to protein and lipid deposits on the lens surface, leading to reduced wettability, discomfort, and eye diseases.11
Therefore, ongoing research aims to enhance oxygen permeability, increase wettability, and reduce protein adsorption to improve contact lens performance.12
In addition to correcting refractive errors and cosmetic reasons, contact lenses are being explored as potential drug delivery systems for treating ocular diseases.13 Drug delivery to the anterior segment of the eye is commonly accomplished through formulations, including solutions, suspensions, and ointments.14,15 However, traditional ophthalmic formulations exhibit low ocular bioavailability due to many factors, including reflex tearing and blinking, incomplete absorption, nasal discharge, poor metabolism, and relative impermeability of the corneal epithelium.16 To compensate for this drawback, drugs must be prescribed frequently to achieve the required therapeutic drug levels in the target tissue.17 Such frequent prescribing not only increases the risk of side effects but also reduces patient compliance. Consequently, there is a growing interest in more effective ocular drug delivery systems.17
Contact lens-based drug delivery systems offer high biocompatibility and efficient drug delivery capabilities. However, due to their thin and structurally limited space, contact lenses face significant challenges in loading a sufficient amount of drugs.18 Additionally, incorporating drugs into contact lenses can alter their mechanical and optical properties, affecting wearer comfort and lens performance.19
There have been many studies on the use of contact lenses for ocular drug delivery.20,21 Ophthalmic drugs released from lenses remain on the corneal surface longer than drops, and contact lenses are easy to load with drugs. Drug delivery via contact lenses may also lead to higher compliance, especially in patients who require refractive correction.22 Escherichia coli isolated from the diseased ocular surface has demonstrated a strong potential for biofilm formation, highlighting its role in persistent infections and antimicrobial resistance.23
Several studies have been conducted on using fatty acids in ocular drug delivery systems. Unsaturated fatty acids, such as oleic acid, linolenic acid, and α-linolenic acid, act as microemulsions for treating ocular diseases.24-26 In vitro and ex vivo studies of oleic acid-based microemulsions have been effective for the ocular delivery of ofloxacin.23 Furthermore, chitosan-coated nanoemulsions based on oleic acid have been found to be a safe means of delivering cataract therapeutics.27
In particular, oleic acid, when used alone, can enhance the corneal permeability of both water- and fat-soluble compounds in vivo and is safe over a wide concentration range. Fatty acid-based drug carriers have the lowest toxicity and are primarily useful for hydrophobic drug delivery. These carriers have low melting points, low viscosity, and relatively high flexibility, which facilitates their use in implant and injection delivery.28
Gatifloxacin is a fourth-generation fluoroquinolone antibacterial agent with a broad antibacterial spectrum and potent antimicrobial activity. In comparative studies, gatifloxacin demonstrated potent antimicrobial activity against a wide range of gram-negative and gram-positive organisms, further supporting its effectiveness in treating ocular infections.29 It is much more effective against gram-positive bacteria compared to ciprofloxacin and sparfloxacin.30,31
Natural polysaccharides are easy to apply to hydrogels and are used in many applications because of their biocompatibility, biodegradability, and excellent mechanical properties.32 Chitosan, alginate, collagen, and hyaluronic acid are examples of natural polysaccharides. They contain hydrophilic functional groups such as hydroxyl, amine, and carboxyl groups that, when applied to contact lenses, can improve water content and wettability and impart antiviral and antimicrobial properties.33
Natural antimicrobial agents have been shown to inhibit biofilm formation and exhibit antimicrobial effects against both gram-positive and gram-negative bacteria. For example, Staphylococcus aureus, a gram-positive bacterium, and Escherichia coli and Pseudomonas aeruginosa, both gram-negative bacteria, respond well to natural antimicrobials.34,35 Chitosan and chito-oligosaccharides, in particular, have demonstrated strong antimicrobial effects, making them suitable for biomedical applications, including drug delivery systems.36 These properties can vary depending on the molecular weight of hyaluronan and chitosan, which affects drug diffusion and mechanical integrity.37
In recent years, techniques such as layer-by-layer (LBL) and interpenetrating polymer network (IPN) have become popular for enhancing the performance of contact lenses and controlling drug release. LBL technique allows for superior control by coating surfaces with biomolecules and cells, colloids, and polymers. LBL coatings using hyaluronan and chitosan have been shown to exhibit antibacterial effects against Staphylococcus aureus and Pseudomonas aeruginosa, supporting the use of LBL techniques for improving contact lens properties.38 This technique involves the sequential adsorption of alternating negatively and positively charged polymers onto the surface.39 The LBL multilayer bond between the negatively charged hyaluronic acid and the positively charged chitosan is formed by the binding of positively and negatively charged polymers (Figure 1). However, LBL coating often result in a reduced drug loading capacity while controlling drug release.40 Studies on Layered Double Hydroxide (LDH) assemblies with LBL polymer coatings have shown that this method can be optimized to increase drug loading capacity while maintaining controlled release behavior.41
Polyelectrolyte layers have been used to control drug release from hydrogels because they can minimize the amount of drug released from the surface, reducing the initial burst release, and act as a barrier that slows down the diffusion of drug particles by reducing the pore size of the contact lens.42,43
This study aims to overcome the limitations of existing drug delivery systems, oleic acid was introduced to improve the drug loading capacity and natural polysaccharides such as hyaluronic acid and chitosan were used to ensure continuous drug release through LbL muticoating.

|
Figure 1 Chemical bond of hyaluronic acid and chitosan. |
Reagents and Materials. The silicone monomer (3-methacryloxy-2-hydropropoxy) propylbis (trimethylsiloxy) methylsilane (SiGMA, GEO specialty chemicals), along with hydrophilic monomers N-vinyl-2-pyrrolidone (NVP) and N,N-Dimethyl acetamide (DMA), were used to prepare the silicone hydrogel contact lenses. Ethylene glycol dimethacrylate (EGDMA) served as the cross-linker, and 2,2-azobisisobutyronitrile (AIBN, Junsei Chemical Co, Japan) was used as a thermal initiator. Gatifloxacin (Santa Cruz Biotechnology, USA), a fluoroquinolone antibacterial agent, was used to investigate the drug release from the contact lenses, and oleic acid, a fatty acid, was used to increase drug loading efficiency. LBL coating was applied using hyaluronic acid (molecular weight: 8000-15000 Da), a natural polysaccharide, and water-soluble low-molecular-weight chitosan (molecular weight: 5000 Da). All reagents used in this study were purchased from Sigma-Aldrich (Korea) except SiGMA, AIBN, and gatifloxacin.
Contact Lens Fabrication. The silicone hydrogel contacts used in this study were prepared using silicone monomer SiGMA and hydrophilic monomers DMA and NVP. EGDMA was the crosslinker for polymerization, and AIBN was the thermal initiator. All samples were agitated with a stirrer for 15 minutes, and the mixed reagents were thermopolymerized at 100 ℃ for 1 h using a 0.00D P.P mold. The polymerized contact lenses were used after separating them from the mold and removing unreacted monomers. The hydrophobic interaction of oleic acid and gatifloxacin was used to increase the drug load. First, oleic acid was prepared at a concentration of 30 mM in ethanol, and the lenses were immersed at room temperature for one day. Then, after soaking in distilled water for 1 h to wash off the remaining ethanol, gatifloxacin was prepared in distilled water at a concentration of 0.3 mg/mL and soaked for one day. Table 1 shows the components and mixing ratios required for preparing the contact lenses.
LBL Multilayer Coating. Multilayer coating with anionic hyaluronic acid and cationic chitosan was performed using the LBL technique to prevent rapid initial release and prolong sustained drug release. First, hyaluronic acid and chitosan were added to deionized water at a ratio of 0.3% each and stirred by ultrasonication for 1 h. After immersion in the hyaluronic acid solution for one minute, the solution that did not stick to the distilled water was removed and then immersed in the chitosan solution for one minute again. This process was repeated twice. Scheme 1 illustrates the multilayer coating process of anionic hyaluronic acid and cationic chitosan using LBL technique.
Scheme 1. Schematic diagram of layer by layer (LBL) coated contact lens using hyaluronic acid and chitosan.
Samples containing no gatifloxacin and oleic acid were labeled R, samples containing only gatifloxacin were labeled G, and those immersed in oleic acid and then gatifloxacin were labeled O. Samples containing the drug and coated only with hyaluronic acid were labeled H, and those containing the drug and coated with chitosan alone were labeled C. The samples double-coated with chitosan on H were labeled HC, and the samples triple-coated with hyaluronic acid on HC were labeled HCH. Lastly, samples coated with four layers of chitosan were labeled HCHC.
Characterization. Light transmittance was measured using a Cary 60 UV-vis spectrophotometer, and the spectral transmittance was measured in the visible region (380 nm-780 nm) following ISO standards.
Water content was measured using the gravimetric method as per ISO 18369-4:2017, Ophthalmic optics Contact lenses Part 4: Physicochemical properties of contact materials. Before measuring the water content, uncoated samples were hydrated in phosphate buffer saline (PBS, 1X, pH7.4) at 37℃ for 24 h, and the samples LBL coated with oleic acid, hyaluronic acid, and chitosan, respectively, were measured 10 times per sample to obtain the average.
Oxygen transmittance was measured using the polarographic method. Oxygen permeability and oxygen transmittance were examined by measuring the current values with a Model 201T O2 permeomterTM (CREATECH, USA) after the samples were treated for at least 2 h inside a WL1000S (WITHLAB, Korea) constant temperature and humidity chamber at 36±0.5 ℃ and 98% humidity.
Contact lens thickness was measured using a Litematic VL-50 (Mitutoyo, Japan). Each sample was measured three times to obtain the average.
Drug Release. The drug release from multilayer-coated samples with natural polysaccharides was examined over 48 h.
The baseline was set with phosphate buffer saline (PBS, 1X, pH7.4) solution, and the absorbance of gatifloxacin in PBS containing each sample was measured over time. The absorbance value at 293 nm, the maximum absorption wavelength of gatifloxacin, was measured using the Agilent Cary 60 UV-vis spectrophotometer. The molar extinction coefficient of gatifloxacin was calculated using ε293nm=8.23×10-4 cm-1M-1 for 1 mg/mL and expressed as the average of three measurements for each sample.
Antimicrobial Properties. To investigate the antimicrobial properties of contact lenses containing gatifloxacin and those LBL coated with hyaluronic acid and chitosan, E. coli (ATCC 10536) was obtained from the Korean Culture Center of Microorganisms. The liquid medium was prepared by mixing 200 mL of distilled water with 0.6 g beef and 1 g peptone, adjusted to pH 7.2, and sterilized with a sterilizer. One μL of E. coli was added to 20 mL of liquid medium and incubated at 37 ℃ for 12 h before use. After hydrating the coated contact lenses in PBS solution for 6 h at room temperature, each sample was placed in a vial with 10 mL liquid medium and incubated at 37 ℃ for 3 h, and then diluted 10000-fold using saline. Finally, a 1 mL smear of the diluted solution was made on a dry film medium (E. coli,3M PetrifilmTM) and incubated at 37 ℃ for 24 h. Each sample was measured three times to obtain the mean Colony-forming unit (CFU).
Statistical Analysis.The statistical analysis of the collected data was performed using SPSS for Windows (Ver. 22). A one-way ANOVA was conducted to compare the light transmittance data among the multilayer-coated samples, followed by a Tukey HSD test for post hoc comparisons to determine significant differences between groups. Additionally, an independent t-testwas applied to evaluate the effects of specific treatments, such as the inclusion of gatifloxacin, oleic acid treatment, and multilayer coating application. All experimental data were presented as mean ± standard deviation (SD), and **statistical significance was set at *p < 0.05, **p < 0.01, ***p < 0.001.
Physical Properties of Multilayer Coated Contact Lenses. Light Transmittance: Light transmittance is the most basic physical property of contact lenses. The visible light transmittance of the samples treated with oleic acid and then multilayer coated with the natural polysaccharides (hyaluronic acid and chitosan) was measured to improve the drug loading efficiency of contact lenses. Figure 2 shows the results.
The light transmittance of R, the most basic sample, was 94.23±0.17%, while G with gatifloxacin was 93.11±0.71%, and O treated with oleic acid was 91.92±0.61%. Compared to R, the transmittance decreased with additional treatments. The transmittance of H and C coated with a single layer of natural polysaccharides was 91.19±0.80% and 91.11±0.01%, respectively. As the number of layers increased with successive coatings, the transmittance tended to decrease: HC (90.71±0.76%), HCH (90.45±0.17%), and HCHC (89.93±0.83%).
Statistical analysis revealed a significant difference in light transmittance among the multilayer-coated groups (H, C, HC, HCH, HCHC) as determined by one-way ANOVA (p < 0.05).
Additionally, an independent t-tests showed significant differences between R and all other samples (p < 0.001), as well as G and O (p < 0.01).
These results are consistent with past studies showing that hydrophobic materials such as gatifloxacin and oleic acid decrease the transmittance of lenses.44,45 However, studies measuring the UV-visible transmittance of silicone hydrogel contact lenses have demonstrated that a slight reduction in transmittance does not impair optical performance, ensuring safe and effective lens use.46
Additionally, similar findings have been reported in multilayer-coated therapeutic contact lenses and intraocular lenses (IOLs), where the addition of coating layers did not compromise visual performance.47,48
These findings collectively suggest that the multilayer coatings applied in this study do not induce visual distortion and effectively maintain the optical functionality of the lenses.
Furthermore, although the light transmittance of the drug-loaded polysaccharide multilayer coated samples decreased to some extent, they remained above 88% according to ANZI Z80.20, the international standard for contact lenses, indicating that their visual properties and characteristics were not compromised.
Water Content: Water content is related to the curvature, thickness, and material of the lens and is one of the most significant factors in determining eye health and the comfort of wearing contacts. Figure 3 shows the water content of each sample.
The water content of R is 65.29±0.72%, while G and O are 66.42±2.12% and 63.28±1.91%, respectively. In general, the presence of hydrophobic drugs in the lens tends to decrease the water content due to their low affinity for water.44 The water content of O decreased due to the hydrophobic interaction of gatifloxacin with oleic acid. The hydrophobic coating of oleic acid reduced the hydrophilic surface area of the lens, thereby reducing the space available for water molecules to be absorbed into the lens.45
LBL-coated contact lenses with natural polysaccharides showed increased water content compared to lenses without LBL coating. In particular, the lenses coated with hyaluronic acid had higher water content than those coated with chitosan because hyaluronic acid contains more hydroxyl (-OH) groups than chitosan, which gives it a greater ability to bind and retain water molecules.49
Additionally, statistical analysis revealed significant differences in water content among the multilayer-coated samples (p < 0.001).
Independent t-test results showed no significant difference between R and G (p = 0.4688), whereas significant differences were observed between R and all other samples (p < 0.001). A significant difference was also observed between O and G (p < 0.01).
These results suggest that LBL coating has a significant impact on water content. Specifically, the fact that natural polysaccharide-coated samples showed significant differences from R indicates that LBL coating with hyaluronic acid and chitosan plays a crucial role in enhancing the hydrophilicity of the lens.49,50
Among them, the significant difference observed between HC and HCH (p < 0.05) suggests that the interactions between alternating layers in the LBL structure may play a more significant role in modulating water content than merely increasing the total number of layers. In this study, it was observed that as hyaluronic acid and chitosan were alternately deposited, the potential for hydrogen bonding increased, which may have led to enhanced water retention.
Conversely, no significant difference was found between the H single-layer coating and multilayer coatings, suggesting that even a single-layer hyaluronic acid coating may be sufficient to achieve a substantial increase in water content. This result implies that while hyaluronic acid coating improves water retention, the effect of additional multilayer coatings does not necessarily lead to a proportional increase in water content. The findings indicate that the role of LBL coatings in modulating water content depends not only on the number of layers but also on the molecular interactions occurring within the multilayer structure.
These findings confirm the results above show that LBL coating with hyaluronic acid significantly improves contact lens hydrophilicity.
Oxygen Transmissibility: Oxygen is an essential component of corneal metabolism, and for contact lens users, oxygen transmissibility is a critical property for ocular health. Figure 4 shows the test results of oxygen transmissibility (10-9(cm×mLO2)/ (sec×mL×mmHg), Dk/t) of the drug-loaded and natural polysaccharide multilayer-coated samples.
The oxygen transmissibility of G was 28.34±0.67 Dk/t, similar to R 29.26±0.42 Dk/t, while O decreased slightly to 27.21±0.94 Dk/t. The decrease in O compared to R showed the same trend as in water content, which is consistent with the theoretical results that the oxygen permeability and water content of hydrogel contact lenses are proportional.51
The oxygen transmissibility of monolayer-coated H and C were 27.01±0.47 Dk/t and 26.64±0.52 Dk/t, respectively, while those of the multilayer-coated HC, HCH, and HCHC samples were 25.77±0.87 Dk/t, 25.02±0.59 Dk/t, and 24.34±0.65 Dk/t, respectively. The oxygen transmissibility tended to decrease slightly as the number of coating layers increased.
As the number of coating layers increased, the oxygen transmissibility decreased even though the water content increased. It appears that the multilayer coating process physically blocked the path of oxygen permeating through the lens.
These results are consistent with a previous study, which showed that polymer coating on the lens surface increases the surface density and limits the space for oxygen to permeate and that multiple layers of coating can impede oxygen permeation, resulting in decreased oxygen transmissibility.52 As the number of LBL coatings increased, oxygen transmissibility gradually decreased. However, previous studies have reported that a minimum oxygen transmissibility of 12 Dk/t is sufficient to maintain corneal health during daily wear,53 while another study suggested that 24 Dk/t is the minimum requirement for daily wear contact lenses.54 The lowest measured oxygen transmissibility in this study, 24.34 Dk/t, exceeds these thresholds, suggesting that the developed lenses maintain an oxygen transmissibility level that remains within the acceptable range for safe long-term use, even with LBL-induced reduction in oxygen permeability.
Furthermore, statistical analysis revealed significant differences in oxygen transmissibility among the multilayer-coated samples (p < 0.001). Additionally, a significant difference was observed between R and all other samples (p < 0.001). These results highlight the impact of multilayer coatings and further support the role of natural polysaccharide-based LBL coatings in maintaining oxygen transmissibility.
Drug Release. Figure 5 shows the amount of gatifloxacin released from oleic acid-treated and multilayer-coated contact lenses over 48 h.
The uncoated G released 68.79 μm of gatifloxacin, while the oleic acid-treated O released the most drug at 206.07 μm. Samples H and C, which were monolayer coated with hyaluronic acid and chitosan, released 104.58 μm and 128.49 μm, respectively (Figure 5(a)). This is likely due to the hydrophobic interaction between gatifloxacin and oleic acid, which attract each other in hydrophilic environments such as water, resulting in better binding of gatifloxacin to the oleic acid-coated surface.55
HC with a double-layer coating released 142.21 μm, HCH with a triple-layer released 106.01 μm, and HCHC with a quadruple-layer released 73.12 μm of the drug.
As shown in Figure 5(a), the uncoated and monolayer-coated samples (G, O, H, and C) all released the drug for up to 3 h and then stopped. The oleic acid-treated O sample showed significantly higher drug release compared to the other monolayer samples due to its increased drug loading capacity, indicating that oleic acid successfully enhances drug loading. On the other hand, the multilayer coated HC and HCH samples released gatifloxacin up to 12 h. The quadruple-layer coated HCHC showed continuous drug release for 48 h.
The contact lenses with no coating layer showed faster drug release than those with an LBL coating of hyaluronic acid and chitosan. Furthermore, the amount of gatifloxacin released gradually decreased as the coating layer accumulated on the lens surface by LBL technique, but the duration of drug release was sustained for a longer period of time.
These results were attributed to the polymeric coating consisting of an ionic bond between anionic hyaluronic acid and cationic chitosan, which controls the diffusion of the drug and blocks its migration,56 and the higher crosslink density on the lens surface compared to monolayer coated lenses, resulting in slower drug release.57,58 Additionally, the molecular weight of the polysaccharides, such as hyaluronic acid and chitosan, plays a critical role in controlling both the drug release kinetics and the mechanical integrity of the multilayer coating.37,41 In this study, it was also demonstrated that long-term drug release was possible by multilayer coating with hyaluronic acid and low-molecular-weight chitosan.
Antimicrobial Properties. Antimicrobial activity was assessed after the gatifloxacin in the contact lenses was released for 6 h. Table 2 and Figure 6 show the results.
R without gatifloxacin showed no antimicrobial activity, as indicated by the growth of too numerous to count (TNTC) bacteria. The results for G and O were 302 CFU/mL and 152 CFU/mL, respectively, emonstrating that the antimicrobial activity improved with oleic acid treatment due to its ability to enhance drug loading. The results for H and C, which were monolayer-coated samples, were 62 CFU/mL and 19 CFU/ml, respectively, suggesting that the antibacterial effect of the sample coated with chitosan, known for its excellent antimicrobial properties, was stronger. In general, chitosan contains positively charged amino groups that effectively inhibit bacterial growth through strong electrical interaction with the negatively charged bacterial cell membrane.58,59
After 6 h, the double-layer HC sample had 3 CFU/ml, the triple-layer HCH sample had 1 CFU/mL, and the quadruple-layer HCHC sample had 0 CFU/ml, indicating that no E. coli was detected. These results indicate that the layer-by-layer (LBL) coating using hyaluronic acid and chitosan demonstrated significant antibacterial effects, consistent with findings from previous studies on the antibacterial activity of LBL coatings against Staphylococcus aureus and Pseudomonas aeruginosa.38 This result further expands upon these findings by confirming that similar antibacterial efficacy can be achieved against E. coli, a gram-negative bacterium, demonstrating the versatility of the LBL approach across different bacterial strains.
While all natural polysaccharide-coated samples showed excellent antimicrobial activity, the multilayer-coated samples showed better results than the monolayer-coated samples. In particular, the triple- and quadruple-layered coated samples showed very high antimicrobial activity. It shows that LBL coatings can maintain the antimicrobial effect for a long time due to the continuous release of gatifloxacin. These results are also consistent with a previous study, which reported that LBL coatings, especially when applied in multiple layers, allow the drug to be released slowly and thus maintain its antimicrobial effect against bacteria for a long period of time.41
Therefore, the antimicrobial properties of multilayer-coated contact lenses can be attributed to a combination of the antibacterial activity of the coating material, chitosan, and the extended drug release time. Due to its structural characteristics and chemical properties, the LBL coating can provide a sustained antimicrobial effect by controlling the release of gatifloxacin. The confirmation of antibacterial efficacy against E. coli in this study reinforces the broader applicability of LBL coatings for different bacterial pathogens.

|
Figure 2 Transmittance of multilayer coated silicone hydrogele contact lenses. The statistical significance was set at *p < 0.05, **p < 0.01, and ***p < 0.001. |

|
Figure 3 Water contents of multilayer coated silicone hydrogel contact lenses. |

|
Figure 4 Oxygen transmissibility of multilayer coated silicone hydrogel contact lenses. |

|
Figure 5 Drug release from silicone contact lenses coated with natural polymers: (a) cumulative release from multilayer coated lenses; (b) cumulative release from uncoated and single-layer coated lenses. |
|
Figure 6 Antimicrobial activity of LBL coated silicone hydrogel contact lenses. |
In this study, silicone hydrogel contact lenses were treated with oleic acid to significantly increase the drug loading of gatifloxacin, and subsequently multilayer coated with hyaluronic acid and chitosan to evaluate their drug release and physical properties.
The LBL-coated lenses showed an increase in water content but a decrease in oxygen permeability. Multilayer-coated samples showed a higher water content than the monolayer-coated samples, and oxygen permeability was inversely proportional to the number of coating layers. Moreover, the oleic acid coating allowed for a higher amount of gatifloxacin to be loaded into the contact lens.
The multilayer-coated samples had a longer sustained drug release than the monolayer-coated samples, and the initial rapid drug release was effectively suppressed. As the number of coating layers increased, the drug release time was further prolonged, resulting in a longer-lasting antimicrobial effect. These findings indicate that multilayer coatings are more effective in regulating drug release than monolayer coatings, thereby maintaining a longer antimicrobial effect.
- 1. Liesegang, T. J. Physiologic Changes of the Cornea With Contact Lens Wear. Eye Contact Lens 2002,28, 12-27.
- 2. Park, Y.; Lee, G.; Park, J.; Jeong, B.; Lee, K. The Long-term Effects of Soft Contact Lens Wear on Corneal Thickness, Curvature and Endothelium. J. Korean Ophthalmol. Soc. 2005, 46, 945-953
- 3. Woo, C.; Lee, H. M. Change of Corneal Shape with Soft Contact Lens Type. J. Korean Ophthalmic Opt. Soc. 2014,19, 111-120.
-

- 4. Tyagi, G.; Collins, M.; Read, S.; Davis, B. Regional Changes in Corneal Thickness and Shape with Soft Contact Lenses. Optom. Vis. Sci. 2010,87, 567-575.
-

- 5. Read, S. A.; Collins, M. J. Diurnal Variation of Corneal Shape and Thickness. Optom. Vis. Sci. 2009,86, 170-180.
-

- 6. Cho, S. A.; Kim, T. H.; Sung, A. Y. Study on Physical Properties of Soft Contact Lens Materials with Isocyanate Group for Durability Improvement. Korean J. Vis. Sci. 2011,13, 127-137.
- 7. Park, H.; Lee, H. M. Changes in Drug Elution Concentration and Physical Characteristics of Soft Contact Lenses Depending on the Initiator and Crosslinker. J. Korean Ophthalmic Opt. Soc. 2014,19, 145-151.
-

- 8. Kim, S. R.; Kang, U.; Seo, B. M.; Park, M. A Study on Dye Elution from the Circle Contact Lenses. J. Korean Ophthalmic Opt. Soc. 2014,19, 171-177.
-

- 9. Nichols, J. J. Growth in Some Specialty Areas and Consensus on Lens Discomfort Highlighted an Otherwise Stable Year. Contact Lens Spectr. 2014,29, 22-28.
- 10. Tran, N.; Yang, M. Synthesis and Characterization of Soft Contact Lens Based on the Combination of Silicone Nanoparticles with Hydrophobic and Hydrophilic Monomers. J. Polym. Res. 2019,26, 143.
-

- 11. Song, J. M.; Kwon, S.; Cho, E. J. Correlation Between Tear Volume and Tear Film Stability and Protein Amount Deposited on Soft Contact Lenses in Dry Eyes. J. Korean Ophthalmic Opt. Soc. 2019, 24, 11-19.
-

- 12. Gholizadeh, S.; Wang, Z.; Chen, X.; Dana, R.; Annabi, N. Advanced Nanodelivery Platforms for Topical Ophthalmic Drug Delivery. Drug Discov. Today 2021,26, 1437-1449.
-

- 13. Raina, N.; Pahwa, R.; Bhattacharya, J.; Paul, A. K.; Nissapatorn, V.; de Lourdes Pereira, M.; Oliveira, S. M.; Dolma, K. G.; Rahmatullah, M.; Wilairatana, P. Drug Delivery Strategies and Biomedical Significance of Hydrogels: Translational Considerations. Pharmaceutics 2022, 14, 574.
-

- 14. Xu, J.; Xue, Y.; Hu, G.; Lin, T.; Gou, J.; Yin, T.; He, H.; Zhang, Y.; Tang, X. A Comprehensive Review on Contact Lens for Ophthalmic Drug Delivery. J. Controlled Release 2018, 281, 97-118.
-

- 15. Bachu, R. D.; Chowdhury, P.; Al-Saedi, Z. H.; Karla, P. K.; Boddu, S. H. Ocular Drug Delivery Barriers—role of Nanocarriers in the Treatment of Anterior Segment Ocular Diseases. Pharmaceutics 2018, 10, 28.
-

- 16. Guzman-Aranguez, A.; Colligris, B.; Pintor, J. Contact Lenses: Promising Devices for Ocular Drug Delivery. J. Ocul. Pharmacol. Ther. 2013,29, 189-199.
-

- 17. Maulvi, F. A.; Soni, T. G.; Shah, D. O. A Review on Therapeutic Contact Lenses for Ocular Drug Delivery. Drug Deliv. 2016,23, 3017-3026.
-

- 18. Horne, R. R.; Judd, K. E.; Pitt, W. G. Rapid Loading and Prolonged Release of Latanoprost from a Silicone Hydrogel Contact Lens. J. Drug Deliv. Sci. Technol. 2017, 41, 410-418.
-

- 19. Kim, E.; Saha, M.; Ehrmann, K. Mechanical Properties of Contact Lens Materials. Eye Contact Lens 2018, 44, S148-S156.
-

- 20. Wuchte, L. D.; DiPasquale, S. A.; Byrne, M. E. In vivo Drug Delivery via Contact Lenses: The Current State of the Field From Origins to Present. J. Drug Deliv. Sci. Technol. 2021, 63, 102413.
-

- 21. Chatterjee, S.; Upadhyay, P.; Mishra, M.; Srividya, M.; Akshara, M. R.; Kamali, N.; Zaidi, Z. S.; Iqbal, S. F.; Misra, S. K. Advances in Chemistry and Composition of Soft Materials for Drug Releasing Contact Lenses. RSC Adv. 2020, 10, 36751-36777.
-

- 22. Jung, H.; Chauhan, A. Ophthalmic Drug Delivery by Contact Lenses. Expert Rev. Ophthalmol. 2012, 7, 199-201.
-

- 23. Ranjith, K.; Arunasri, K.; Reddy, G. S.; Adicherla, H.; Sharma, S.; Shivaji, S. Global Gene Expression in Escherichia coli, Isolated from the Diseased Ocular Surface of the Human Eye with a Potential to Form Biofilm. Gut Pathogens 2017, 9, 15.
-

- 24. Vandamme, T. F. Microemulsions as Ocular Drug Delivery Systems: Recent Developments and Future Challenges. Prog. Retin. Eye Res. 2002,21, 15-34.
-

- 25. Üstündag-Okur, N.; Gökçe, E. H.; Eğrilmez, S.; Özer, Ö.; Ertan, G. Novel Ofloxacin-loaded Microemulsion Formulations for Ocular Delivery. J. Ocul. Pharmacol. Ther. 2014, 30, 319-332.
-

- 26. Kumar, R.; Sinha, V. R. Preparation and Optimization of Voriconazole Microemulsion for Ocular Delivery. Colloids Surf. B 2014,117, 82-88.
-

- 27. Shen, J.; Liu, X.; Zhou, M.; Liu, H. Novel Nanoemulsion Formulation for Ocular Drug Delivery for Cataract Therapeutics. J. Biomater. Tissue Eng. 2018, 8, 647-657.
-

- 28. Güç, E.; Gündüz, G.; Gündüz, U. Fatty Acid Based Hyperbranched Polymeric Nanoparticles for Hydrophobic Drug Delivery. Drug Dev. Ind. Pharm. 2010, 36, 1139-1148.
-

- 29. Thornsberry, C.; Sahm, D. F.; Kelly, L. J.; Critchley, I. A.; Jones, M. E.; Evangelista, A. T.; Barth, A. Comparative in vitro Activity of Gatifloxacin, Grepafloxacin, Levofloxacin, Moxifloxacin, and Trovafloxacin Against 4151 Gram-negative and Gram-positive Organisms. Diagn. Microbiol. Infect. Dis. 1999, 33, 269-277.
-

- 30. Brar, R. K.; Jyoti, U.; Patil, R. K.; Patil, H. C. Fluoroquinolone Antibiotics: An Overview. Adesh Univ. J. Med. Sci. Res. 2020, 2, 26-30.
-

- 31. Parmar, P.; Salman, A.; Kalavathy, C. M.; Kaliamurthy, J.; Prasanth, D. A.; Thomas, P. A.; Jesudasan, C. A. N. Comparison of Topical Gatifloxacin 0.3% and Ciprofloxacin 0.3% for the Treatment of Bacterial Keratitis. Am. J. Ophthalmol. 2006, 141, 282-286.
-

- 32. Ko, N.; Lee, H. M. Effect of Ionic Natural Polysaccharides on the Functional Enhancement of Porous Hydrogel Contact Lenses. Polym. Korea 2020,44, 625-632.
-

- 33. Kwiecień, I.; Kwiecień, M. Application of Polysaccharide-based Hydrogels as Probiotic Delivery Systems. Gels 2018,4, 47.
-

- 34. Mohamed, M.; Al-Ashqar, A.; Paray, B. A.; Al-Sadoon, M. K.; Al-Sum, E. M. Melittin and Its Potential in the Destruction and Inhibition of the Biofilm Formation by Staphylococcus aureus, Escherichia coli and Pseudomonas aeruginosa Isolated from Bovine Milk. Microb. Pathog. 2018, 118, 209-218.
-

- 35. Mohamed, M.; Othman, N. H.; Paray, B. A.; Al-Sadoon, M. K.; Al-Sum, E. M. Effects of Selected Malaysian Kelulut Honey on Biofilm Formation and the Gene Expression Profile of Staphylococcus aureus, Pseudomonas aeruginosa, and Escherichia coli. Front. Microbiol. 2018, 9, 1117.
- 36. No, H. K.; Meyers, S. P.; Prinyawiwatkul, W.; Xu, Z. Antimicrobial Effects of Chitosans and Chitooligosaccharides Upon Staphylococcus aureus and Escherichia coli in Food Model Systems. Int. J. Food Microbiol. 2007, 99, 253-262.
-

- 37. Kujawa, P.; Moraille, P.; Sanchez, J.; Badia, A.; Winnik, F. M. Effect of Molecular Weight on the Exponential Growth and Morphology of Hyaluronan/chitosan Multilayers: A Surface Plasmon Resonance Spectroscopy and Atomic Force Microscopy Investigation. J. Am. Chem. Soc. 2005, 127, 9224-9234.
-

- 38. Hernandez-Montelongo, J.; Lucchesi, E. G.; Gonzalez, I.; Macedo, W. A. A.; Nascimento, V. F.; Moraes, A. M.; Beppu, M. M.; Cotta, M. A. Hyaluronan/Chitosan Nanofilms Assembled Layer-by-Layer and Their Antibacterial Effect: A Study Using Staphylococcus aureus and Pseudomonas Aeruginosa. Colloids Surf., B 2016, 140, 427-434.
-

- 39. Richardson, J. J.; Cui, J.; Bjornmalm, M.; Braunger, J. A.; Ejima, H.; Caruso, F. Innovation in Layer-by-layer Assembly. Chem. Rev. 2016,116, 14828-14867.
-

- 40. Silva, D.; Pinto, L. F. V.; Bozukova, D.; Santos, L. F.; Serro, A. P.; Saramago, B. Chitosan/Alginate Based Multilayers to Control Drug Release from Ophthalmic Lens. Colloids Surf., B 2016, 147, 81-89.
-

- 41. Lv, F.; Xu, L.; Zhang, Y.; Meng, Z. Layered Double Hydroxide Assemblies with Controllable Drug Loading Capacity and Release Behavior as Well as Stabilized Layer-by-layer Polymer Multilayers. ACS Appl. Mater. Interfaces 2015, 7, 19215-19223.
-

- 42. Baldwin, E. T.; Wells, L. A. Hyaluronic Acid and Poly-l-Lysine Layers on Calcium Alginate Microspheres to Modulate the Release of Encapsulated FITC-Dextran. J. Pharm. Sci. 2021, 110, 2472-2478.
-

- 43. Silva, D.; de Sousa, H. C.; Gil, M. H.; Santos, L. F.; Moutinho, G. M.; Serro, A. P.; Saramago, B. Antibacterial Layer-by-layer Coatings to Control Drug Release From Soft Contact Lenses Material. Int. J. Pharm. 2018,553, 186-200.
-

- 44. Maulvi, F. A.; Parmar, R. J.; Shukla, M. R.; Desai, A. R.; Desai, D. T.; Ranch, K. M.; Shah, S. A.; Sandeman, S.; Shah, D. O. Plackett-Burman Design for Screening of Critical Variables and Their Effects on the Optical Transparency and Swelling of Gatifloxacin-pluronic-loaded Contact Lens. Int. J. Pharm. 2019,566, 513-519.
-

- 45. Aguirre-Loredo, R. Y.; Rodríguez-Hernández, A. I.; Chavarría-Hernández, N. Physical Properties of Emulsified Films Based on Chitosan and Oleic Acid. CyTA-J. Food 2014,12, 305-312.
-

- 46. Fuentes, R.; Fernández, E.; Pascual, I.; García, C. UV-visible Transmittance of Silicone-hydrogel Contact Lenses Measured with a Fiber Optic Spectrometer. Proc. SPIE 2013, 8785, 1119-1127.
-

- 47. Wang, R.; Lu, D.; Wang, H.; Zou, H.; Bai, T.; Feng, C.; Lin, Q. Kill-release Antibacterial Polysaccharides Multilayer Coating Based Therapeutic Contact Lens for Effective Bacterial Keratitis Treatment. RSC Advances 2021,11, 26160-26167.
-

- 48. Lin, Q.; Xu, X.; Wang, B.; Shen, C.; Tang, J.; Han, Y.; Chen, H. Hydrated Polysaccharide Multilayer as An Intraocular Lens Surface Coating for Biocompatibility Improvements. J. Mater. Chem. B 2015, 3, 3695-3703.
-

- 49. Wang, Y.; Guo, L.; Ren, L.; Yin, S.; Ge, J.; Gao, Q.; Luxbacher, T.; Luo, S. A Study on the Performance of Hyaluronic Acid Immobilized Chitosan Film. Biomed. Mater. 2009,4, 035009.
-

- 50. Lin, C.; Cho, H.; Yeh, Y.; Yang, M. Improvement of the Surface Wettability of Silicone Hydrogel Contact Lenses via Layer-by-layer Self-assembly Technique. Colloids Surf B 2015, 136, 735-743.
-

- 51. Giedd, B. Understanding the Nuances of Contact Lens Materials. Contact Lens Spectr. 1999, 14, 23-28.
- 52. Kim, H. J.; Lee, H. M. Drug Release and Physical Properties of Double Layers Coated Contact Lenses Using Natural Polymers. Macromol. Res. 2024, 10, 981-988.
-

- 53. Benjamin, W. J. Downsizing of Dk and Dk/L: the Difficulty in Using hPa Instead of MmHg. Int. Contact Lens Clin. 1996, 5, 188-189.
-

- 54. Holden, B. A.; Mertz, G. W. Critical Oxygen Levels to Avoid Corneal Edema for Daily and Extended Wear Contact Lenses. Invest. Ophthalmol. Vis. Sci. 1984, 25, 1161-1167.
-

- 55. ten Wolde, P. R. Hydrophobic Interactions: An Overview. J. Phys. Condens. Matter. 2002, 14, 9445-9450.
-

- 56. Bonechi, C.; Tamasi, G.; Donati, A.; Leone, G.; Consumi, M.; Cangeloni, L.; Volpi, V.; Magnani, A.; Cappelli, A.; Rossi, C. Physicochemical Characterization of Hyaluronic Acid and Chitosan Liposome Coatings. Appl. Sci. 2021, 11, 12071.
-

- 57. Wang, H.; Gong, X.; Guo, X.; Liu, C.; Fan, Y.; Zhang, J.; Niu, B.; Li, W. Characterization, Release, and Antioxidant Activity of Curcumin-loaded Sodium Alginate/ZnO Hydrogel Beads. Int. J. Biol. Macromol. 2019,121, 1118-1125.
-

- 58. Singh, D. K.; Ray, A. R. Biomedical Applications of Chitin, Chitosan, and Their Derivatives. J. Macromol. Sci., Part C: Polym. Rev. 2000,40, 69-83.
-

- 59. Lopez-Pena, C. L.; McClements, D. J. Optimizing Delivery Systems for Cationic Biopolymers: Competitive Interactions of Cationic Polylysine with Anionic κ-carrageenan and Pectin. Food Chem. 2014,153, 9-14.
-

- Polymer(Korea) 폴리머
- Frequency : Bimonthly(odd)
ISSN 2234-8077(Online)
Abbr. Polym. Korea - 2025 Impact Factor : 1.0
- Indexed in SCIE
 This Article
This Article
-
2025; 49(4): 425-434
Published online Jul 25, 2025
- 10.7317/pk.2025.49.3.425
- Received on Nov 18, 2024
- Revised on Feb 17, 2025
- Accepted on Feb 17, 2025
 Services
Services
- Full Text PDF
- Abstract
- ToC
- Acknowledgements
- Conflict of Interest
Introduction
Experimental
Results and Discussion
Conclusions
- References
Shared
 Correspondence to
Correspondence to
- Yoon Jung Jang* , and Hyun Mee Lee
-
Department of Optometry and Vision Science, Daegu Catholic University, Gyeongbuk 38430, Korea
*Chunma College of General Studies, Yeungnam University, Gyeongbuk 38541, Korea - E-mail: jyj5014@ynu.ac.kr, hmlee@cu.ac.kr
- ORCID:
0000-0002-7192-3211, 0000-0001-6668-5864










 Copyright(c) The Polymer Society of Korea. All right reserved.
Copyright(c) The Polymer Society of Korea. All right reserved.